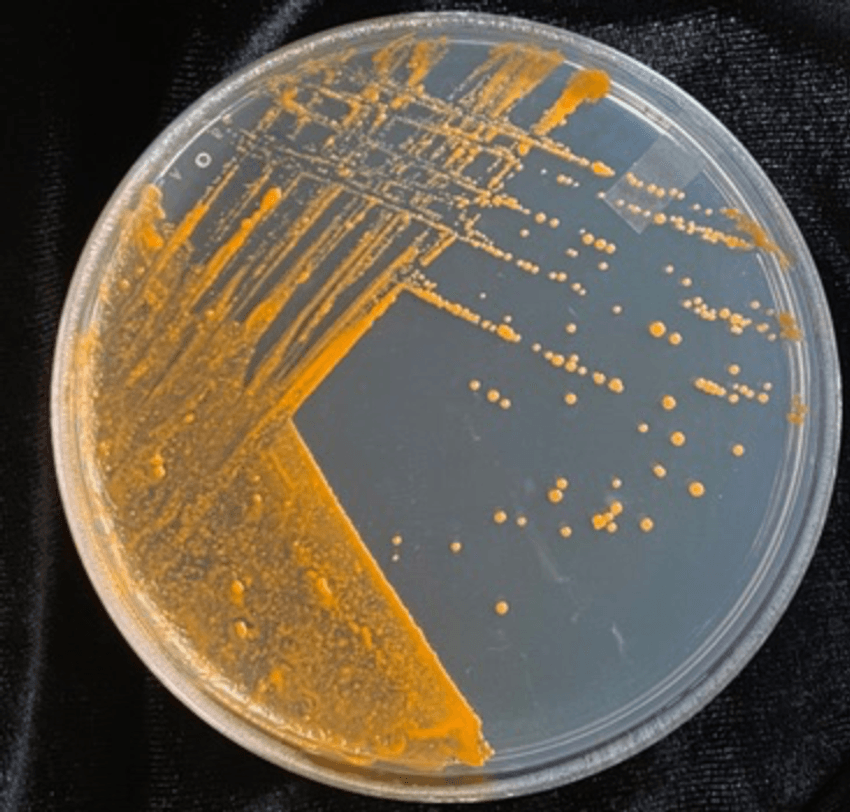

Gordonia alkanivorans, a species of bacteria that lives on grapevines, could degrade guaiacol, the main chemical compound that makes wine from grapes exposed to wildfire smoke taste like smoke and ash.
Most people prefer their wine sans the strong hint of wildfire smoke. But this ashy taste, also known as smoke taint, doesn’t seem to bother Gordonia alkanivorans, rod-shaped bacteria that live on grapevines.
Recently, researchers discovered that G. alkanivorans could degrade guaiacol, the main volatile compound that causes smoke taint.1 Their findings, published in PLoS ONE, may someday allow winemakers to remove the taste of wildfire smoke and ash from wine, an issue that has cost the industry millions of dollars.
“What I think is really interesting about this study is that they’re able to target, potentially, just the guaiacol,” said Cole Cerrato, a chemist at Oregon State University who was not associated with the new research. Cerrato explained that current techniques, such as activated charcoal, that could remove smoke taint from wine also pull out “all the good stuff [people] typically associate with wine,” for instance, its vibrant colors and subtle flavors. “This study showed that there is a potential to have some kind of specificity.”
Researchers cultured bacteria from grape leaves and discovered that Gordonia alkanivorans could degrade guaiacol but not related compounds.
Claudia Castro, CC-BY 4.0 (https://creativecommons.org/licenses/by/4.0/)
Thanks to climate change, wildfires are burning bigger and hotter, producing large clouds of smoke that grapevines soak up like sponges. Enzymes in grape leaves and fruits modify the volatile chemicals in smoke, such as guaiacol, leaving smoke taint in the wine they produce. Although guaiacol is toxic to most bacteria, researchers have found some species that could degrade this compound.2-6 However, these bacteria typically live in soil, not on grapevines.
Tom Collins, an analytical chemist at Washington State University, in collaboration with Claudia Castro and Devin Coleman-Derr, researchers at the United States of America Department of Agriculture, wanted to know if any of the bacteria that naturally colonize grape leaves and fruits could also metabolize guaiacol.
To address this question, the researchers isolated bacteria from the leaves of Chardonnay- and Cabernet Sauvignon-producing grapevines. While winemakers don’t use grape leaves to make wine, some leaves often end up harvested alongside fruits, and consequently, get included in the fermentation process. Leaves also represent most of a plant’s surface area.
“When you have a smoke exposure, most of the smoke is actually going to impact the leaves rather than the fruit,” Collins said. “And there’s some evidence that some of these compounds can translocate from the leaves to the fruits.”
The researchers cultured the leaf bacteria in media containing minimal nutrients, which they supplemented with guaiacol as the bacteria’s only source of carbon, a critical element for growth and survival. The team discovered that one species, G. alkanivorans, could use guaiacol—but not its related compounds that are also present in smoke—as their sole carbon source. This surprised Collins. “There’s still room to evaluate why they’re so selective,” he said.
To understand the molecular mechanisms behind G. alkanivorans’s ability to metabolize guaiacol, the researchers performed RNA sequencing and looked for genes that became more active after the addition of guaiacol. They found that the expression of two genes, guaA and guaB, were consistently upregulated 20, 60, and 300 minutes after guaiacol supplementation. When the researchers knocked out guaA, which encodes the enzyme cytochrome P450, G. alkanivorans could no longer metabolize guaiacol, suggesting that the gene played a critical role in this process.
“It’d be great if we could find a set of enzymes that would be able to target the other smoke phenols, like this one, then purify them,” Cerrato said. On a similar note, Collins hopes to identify other microbes that can degrade other chemicals in smoke besides guaiacol. He also wants to understand what environmental factors, such as the type of smoke and how much of it, affect the abilities of different bacteria to metabolize volatile compounds in smoke.
“Once we understand that, then we can develop methods for application, whether it’s inoculating certain microbes in the vineyard ahead of a smoke exposure or maybe in the wake of smoke exposure,” Collins said. “Those are still a little bit [of a] ways down the road.”